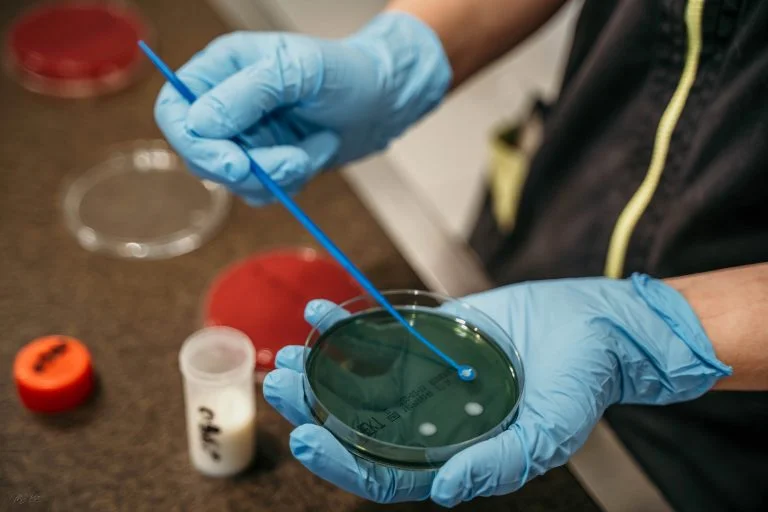

La clinique
La localisation
La Clinique Vétérinaire des Gentianes est située dans la vallée de Morteau, entre Maiche et Pontarlier (à 30 Km) et à 10 Km de la frontière suisse. La structure se trouve dans la zone d’activités de Morteau, facile d’accès et beaucoup de parkings à disposition.

L'équipe
L’équipe est à ce jour composée de 3 vétérinaires associés, 4 vétérinaires salariés, 3 ASV (Auxiliaire Spécialisé Vétérinaire) et 1 secrétaire comptable.
Honnêteté, explications, prévention, formation continue restent les maîtres mots de notre activité, en espérant proposer des soins de qualité et leur suivi au juste prix sans tomber dans l’extrême acharnement diagnostique ou thérapeutique.
les infrastructures
La création de la structure date de 1991 quand les deux cabinets vétérinaire de Morteau et du Russey se sont fusionné aux Fins donnant lieu à La Clinique des Gentianes avec 4 vétérinaires associés. Le bâtiment a pris la place de l’ancien Haras destiné à la reproduction des chevaux. Depuis, tout le quartier a été transformé en zone d’activité commerciale très dynamique.
Aller à
Accueil
L’accueil des patients et des ses propriétaires est une de nos priorités. La prise de rendez-vous pour les consultations est indispensable pour pouvoir vous réceptionner dans les meilleures conditions et, même en cas d’urgence, nos assistantes sont formées pour apporter les premiers soins dès l’arrivée du patient. Nous privilégions les relations avec le client et malgré l’emploi du temps contraignant des vétérinaires, nous cherchons de satisfaire au mieux les propriétaires en laissant le libre choix du vétérinaire traitant. Ceci est important pour le suivi des soins de vos animaux.
Salles de consultations
Les vétérinaires ont 2 salles de consultation à leur disposition pour tout ce qui concerne la médecine générale et les examens diagnostiques simples. Nos plages de rendez-vous sont d’au moins trente minutes, même pour les rappels de vaccination, pour pouvoir consacrer le temps nécessaires à vos questions.
Salles d’imagerie
La salle d’imagerie nous permet d’effectuer des échographies et des radiographies en toute sécurité. Ceux sont des examens complémentaires qui nous permettent de poserun diagnostique, en cas de fracture d’une patte par exemple, ou parfois vérifier l’évolution d’une gestation.
Le Dr. Gillier effectue depuis plusieurs années des écho-cardiographies pour diagnostiquer des problème cardiaques.
Dans cette salle nous effectuons aussi des séances laser, une nouvelle technologie qui exploite les ondes électromagnétiques de la lumière pour la gestion de la douleur, l’inflammation et la cicatrisation des plaies.
Le Plateau Technique
Nous avons créé dans notre structure un vrai laboratoire d’analyses biochimiques nous permettant d’effectuer en temps réel des examens du sang, des dosages hormonaux, des numérations formule pour toutes les espèces. Des examens microbiologiques sont réalisés grâce au microscope et à l’étuve, utilisée pour effectuer des bactériologies sur gélose et des antibiogrammes pour cibler les traitements.
Salle de chirurgie
Nous effectuons la plupart des chirurgies pendant la matinée pour pouvoir rendre les animaux bien réveillés dans l’après-midi, sauf cas particuliers comme les chirurgies d’urgence. L’équipement qu’on retrouve dans cet espace est très technique pour permettre la meilleure surveillance aux animaux endormis et donner du confort au chirurgien : lampe chirurgicale au plafond, anesthésie gazeuse, tables électriques….
Nous mettons à disposition régulièrement cette salle pour les chirurgies d’ostéosynthèse ou oncologiques complexes pour notre chirurgien itinérant de confiance qui nous aide à vous offrir un service de pointe.
Salle de préparation
Cette espace est comme un SAS avant de rentrer dans la salle de chirurgie: pose des cathéters veineux, des sondes endotrachéales… Les animaux sont endormit et préparés stérilement, ensuite déplacés pour la chirurgie; ici nous effectuons aussi des petite intervention qui ne nécessitent pas d’asepsie comme des détartrage ou la tonte sous anesthésie.
Hospitalisations
Le local d’hospitalisation est utilisé pour le réveil des animaux après les chirurgies ou pour la surveillance des animaux malades pendant plusieurs jours. La surveillance pendant les horaires de fermeture est assurée par le vétérinaire de garde par le biais d’une caméra de surveillance connectée.
Isolement malades contagieux
Cet espace est réservé aux animaux atteints d’une pathologie contagieuse et isolé des autres pièces de la clinique. Seul le personnel avec un équipement à usage unique accède à cet endroit qui est désinfecté après chaque hospitalisation. L’isolement des animaux est adopté dans des cas spéciaux et nous permet de réduire les risques d’infections nosocomiales.
Cliniques partenaires
Il est bien connu que l’union fait la force. Forts de cet adage, nous avons développé avec la Clinique Vétérinaire du Val et la Clinique Vétérinaire des Chanois, une relation d’entente et de partage de nos connaissances et de nos ressources.
Par de multiples échanges, nous cherchons ensemble la meilleure solution pour chacun de nos patients, faisant ainsi appel aux différentes compétences spécialisées présentes dans chaque structure. Cela nous permet de vous offrir un service varié et de qualité et surtout de proximité.
Pour les examens complémentaire complexes, comme le scanner, nous référons nos cas à des cliniques référés régionales les plus proches en transmettant le dossier du patient et en accompagnant le propriétaire dans la prise de rendez-vous.
Enfin, pour les chirurgies spécialistiques, nous faisons appel au Dr. Fabien Arnaud de la Clinique Zebrasoma de Strasbourg, vétérinaire chirurgien itinérant diplomé européen, qui peut intervenir dans nos locaux pour éviter le déplacement aux propriétaires.
Notre souhaite est de vous apporter un service complet et visé à amener les meilleurs soins à vos animaux.